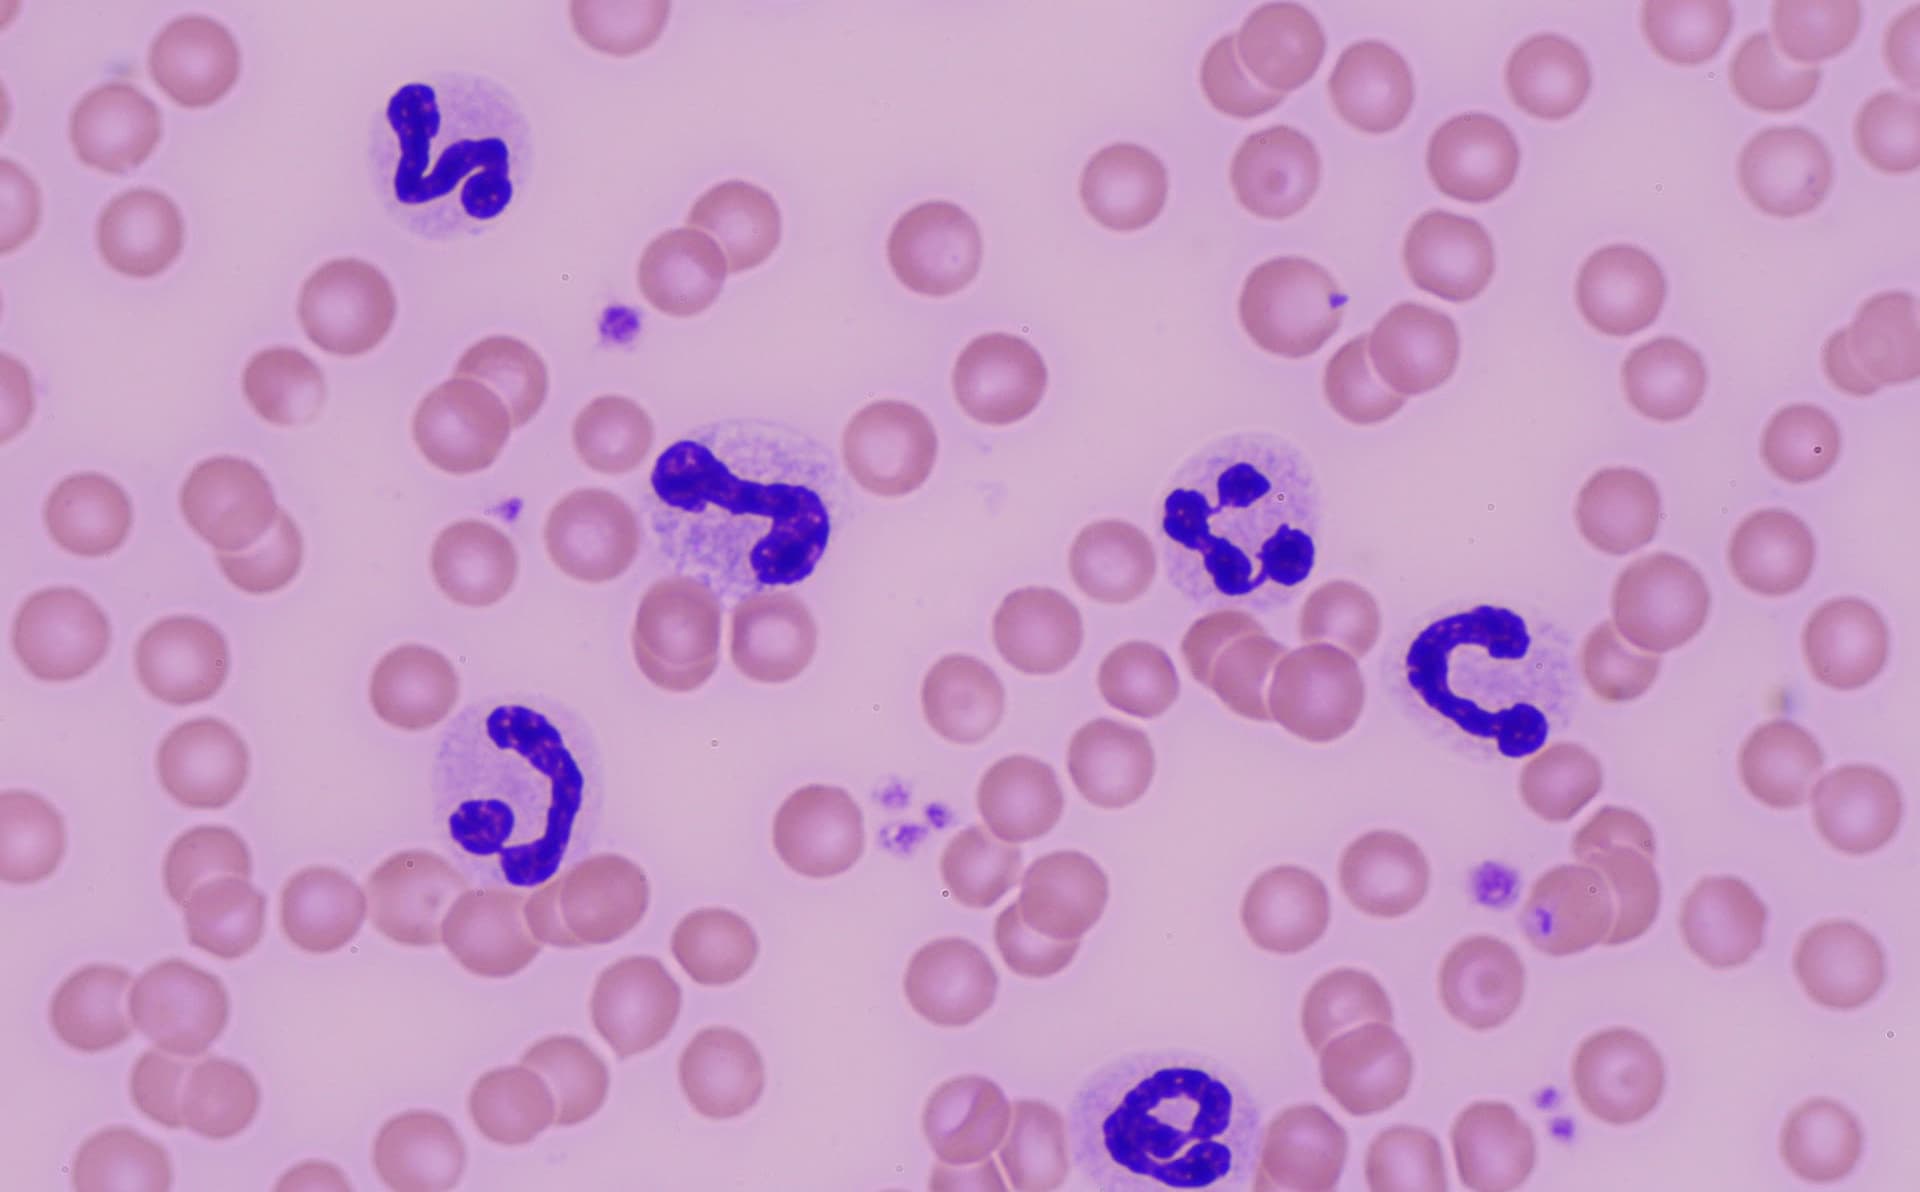

2021/04/07
「見える」について。
視力の話じゃありません
この一枚でいろいろ分かります。
ふじみ野市の大井みどり動物病院です。
中学生の頃、「見える」と「見えない」についての授業がありました。
視力の問題ではななく、その人の立場、経験や成熟度などによって、その現象が理解できるかどうかの話だったと記憶しています。
ところで、この写真は顕微鏡でみた、血液細胞の写真です。
この写真だけで、緊急事態で、即入院するのが良いと言えます。
犬であり、細菌感染を起こしており、体の中に膿がたまっていたり、腸の菌が血液中に入ってしまったりしている可能性が高いからです。
大きな細胞が好中球、中くらいのが赤血球、小さいのが血小板です。
この好中球の形態が普通ではないのです。通常の時と、違う顔をしています。
私は、この一枚から、危ないから入院をした方が良いと担当医に伝えました。
詳しく聞くと、糖尿病を患っているワンちゃんでした、エコー検査で、腎臓周りに液体が貯留しており、その液体を採取すると膿でした。
即入院し、抗生剤の投与などにより、軽快しました。数日様子をみたら、命の危険があったでしょう。
獣医師として駆け出しの頃は、これが「見えなかった」です。でも、今は「見える」ようになりました。
見えなかったら、もしかしたら、助からなかったかもしれません。見えることで、助かったのだと信じています。
これからも、もっと、たくさんの事を、「見える」ようになりたいと願っています。
医療はわからない事だらけですから、題材には一生困りませんけど。
受付時間
| 受付時間 | 月 | 火 | 水 | 木 | 金 | 土 | 日祝 |
|---|---|---|---|---|---|---|---|
| 9:50-12:45 | ○ | ○ | 休 | ○ | ○ | ○ | ○ |
| 15:50-18:45 | ○ | ○ | 休 | ○ | ○ | ○ | ○ |
水曜休診
夏季休業なし
12月30日から1月3日休診

